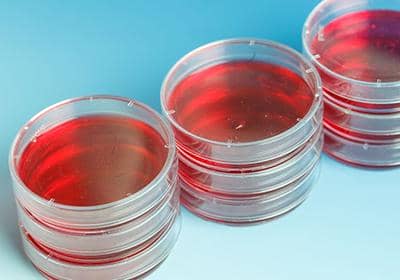
基礎(chǔ)型細(xì)胞培養(yǎng)基的成分主要有哪些?各有哪些作用?

国产 欧美 日韩在线播放|
成年人午夜视频免费在线观看|
99久久中出中文字幕|
91porn国产在线观看|
2020无码专区人妻系列日韩|
八重神子ちゃんが部下を腿法|
中文字幕综合av一区二区三区|
中文字幕有码亚洲大片视频 |
69久久久久久91精品人妻|
91中文字幕亚洲人妻|
成人熟女一区二区三|
丰满的熟妇岳中文字幕|
国产AV国片精品JK制服|
丁香色婷婷五月激情|
波多野无码中文字幕av专区|
最近最好最新2018中文字幕免费|
粉色视频视频APP免费观看|
波多野给我结衣乳|
八七福利六九国产在线 |
成人区亚洲区无码区在线|
国产成人AV无码一区在线播|
91欧美在线播放|
91社区福利免费体验30秒|
波多野吉衣中文字幕|
99久久婷婷国产综合精品青草欧美成人|
最近新免费韩国直播视频|
91久久精品人人人妻人69|
av午夜福利网址|
7788成年網站免費觀看|
成人精品一区日本无码网|
99久久精品国产麻豆的更新时间|
国产办公室秘书无码精品99 |
最新中文字幕在线观看一区|
成人午夜福利片免费观看|
最新2022久久国产精品网站 |
草莓视频app下载无限看|
高清中文字幕成人AV|
91色漫在线ios手机版安装 |
八七福利六九国产在线 |
综合激情中文字幕一区|
大学生一级毛片高清版|
成人亚洲A区啊啊啊 |
91麻豆精品国产|
成人免费在线观看h视频|
91在线精品中文字幕在线|
97在线午夜免费视影院|
91自拍偷拍在线|
www.日韩欧美国产|
丰满的熟妇岳中文字幕|
18禁久久精品乱码|
18以下禁止观看的1000部视频|
被主人各种玩具姿势c到爆|
成人 欧美 日韩 在线 |
最新中文字幕在线观看一区|
AV手机在线播放网站 |
91亚洲国产成人久久精品蜜臀|
99久久久国产精品免费爽爽|
成人看片黄a在线|
国产91精品一区二区蜜臀|
高清欧美日韩在线|
调教超级yin荡玩物学生h|
高清精品一区二区三区|
91香蕉视频软件|
福利姬液液酱喷水视频在线观看|
中文字幕一区婷婷久久
|
av免费在线一区二区三区|
国产97免费视频|
se01在线看片|
104国产一级拍拍视频|
2019年国产一级毛片|
国产18成人三级在线观看|
港台三级欧美aⅴ野花喷水|
91精品视频在线观看91|
超碰伊人久久精品青草热|
大香伊人久久精一飞二飞|
爆播国产三级片在线视频|
97成人超碰精品|
18禁美女黄网站色大片免费看|
18禁止观看免费私人影院|
中文字幕伊人精品|
国产百合高潮视频在线观看
|
91在线精品视频 |
岛国成人一区二区在线观看网址|
大学生一级毛片高清版|
91亚洲国产日韩欧美在线播放
|
99亚洲综合精品成人网色播 |
中文字幕亚洲一区二区∨a在线|
18SCHOOL第一次破苞摘花|
成人看片黄a在线|
国产av一区二区三区天|
99国产精品欧 |
成人啪精品视频免费|
中文字字幕在线中文人妖|
福利姬国产精品一区在线|
18禁久久精品乱码|
国产A在亚洲线播放|
成年美女黄网站色大片不卡|
国产69精品亚洲黄片大全|
35sao在线视频免费播放|
成年无码AV片完整版|
18未满禁止免费69影院|
爱爱欧美视频一区二区三区|
惨遭蹂躏的大学校花|
99pao成人永免费视频|
扒开腿挺进湿润的花苞hd视频|
国产+成+人+亚洲欧洲自线 |
国产91高清免费|
东京热高清无码精品|
波多野给我结衣乳|
91九色亚洲国产|
成人 福利在线观看|
18禁止观看免费私人影院|
苍井空三点高清线视频|
av高清在线一区二区三区|
a级在线观看免费|
波多野结衣无码人妻三区|
99精品视频只有精品|
国产ⅤA免费精品高清在线观看 |
国产2020乱码一二区|
大地资源影视中文版|
97久久免费视频|
中文字幕一级AV |
国产成a人片777777久久|
2019年国产一级毛片|
91av电影一区二区|
369看片天堂你懂的电影|
成人 欧美 日韩 在线 |
yw视频国产在线综合区|
97色精品一区二区在线观看|
成年女人www国产精品|
成人欧美网站免费|
国产v亚洲v天堂无码 |
办公室员工的滋润3|
成人小视频在现一区二区|
丁香色婷婷五月激情|
国产av中国国产精品|
国产911精品一二三区不卡|
丰满儿媳妇好紧好浪|
顶级欧美熟妇高潮xxxxx|
潮喷大喷水系列无码|
7777色情网黄A片免费看蜜臀|
最新亚洲中文字幕欧美一区
|
A∨在线免费不卡可看|
成人免费在线午夜|
东京热无码人妻系列综合|
国产ZZJJZZJJ视频全免费|
高清欧美日韩在线|
成年片精品69情趣99hd|
成人Aⅴ免费视频在线观看网站|
JZZIJZZIJ日本成熟少妇|
福利导航av天堂中文在线|
1024大香蕉手机看片|
电影天堂在线观看高清|
成年在线观看视频|
337p欧美日本超大胆艺术裸|
成人在线免费播放|
99久久久国产免费观看视频|
高清高速无码一区二区|
91在线国产精品无马|
91午夜福利国产 |
gogo人体高清大胆亚洲av|
av在线亚洲网站|
a级在线观看免费|
打扑克又叫视频软件|
丁香久久五月婷婷社区|
yw视频国产在线综合区|
成人精品三级网站大全|
成在线人视频免费视频无遮挡 |
337p粉嫩胞人体高清视频免费|
18禁白丝JK自慰喷水无码|
中文字幕一精品亚洲无线一区 |
成人午夜影院在线观看免费|
成人片黄网站色大片免费无码|
吃瓜黑料视频永久地址 |
国产ⅤA免费精品高清在线观看 |
超碰国产公开caoprom|
成人国产毛片2022年|
2019年国产一级毛片|
av无码小缝喷白浆在线观看
|
2019免费一级黄片|
高清视频在线观看一区二区三区|
传说之下羊妈挤羊奶网站|
中文字幕亚洲一区二区三区 |
丁香六月激情综合久久久久|
91中文字幕亚洲国产|
成年午夜免费影院|
最新亚洲中文在线播放|
高清在线观看中文欧美|
别插我B嗯啊视频免费 |
东京热人妻系列无码专区|
91欧美精品午夜性色福利在线|
成人毛片18女人毛片免费 |
av在线国产盗摄ed|
成人黄色视频下载|
国产av麻豆mag剧集 |
北京模特刘倩与老外|
综合国产免费自拍|
自拍偷拍亚洲欧美中文字幕|
18禁裸乳无遮挡免费网站|
91精品欧美综合在线观看最新|
成人免费在线午夜|
啊灬啊灬啊灬快灬深用口述|
www.欧美日韩国产在线 |
2016手机看欧美日韩一本到|
www.国产日韩欧美.com|
91久久精品一区二区ww网站|
99在线免费视频观看 |
aa大片成人免费网站|
ww国产野鸡网一区视频|
最刺激的国产av中文字幕|
99亚洲综合精品 |
综合精品无码在线观看|
中文字幕欧美亚洲一区|
国产av一区二区三区四区|
中文字幕有码亚洲大片视频 |
www.欧美日本在线观看 |
东京热毛片不卡二三区|
囯产毛片久久久久久|
99久久无码一区人妻A片 |
www日本在线视频|
97se国产综合精品一区二区|
99国产成人综合久久|
超清首页国产亚洲丝袜|
91成人在线视频精品|
被入高潮的视频在线免费观看|
99午夜啪啪日本熟妇乱子?片
|
高潮无码精品色欲av午夜福利|
办公室的超薄丝袜人妻献身|
苍井空三点高清线视频|
91中文字幕亚洲国产|
成人一二三区视频|
最近亚洲中文字幕 |
99欧美成人精品高清|
成人午夜亚洲精品无码网站|
yw视频国产在线综合区|
最新中文字幕有码在线播放|
91精品国产观看免费|
成人午夜福利大片|
91视频这里只有|
国产AV无码专区亚洲AV麻豆|
99久久精品久久久久久婷婷
|
成人黄色电影下载 |
最近中文字幕完整视频高清|
91久久香蕉国产熟女视频|
大香蕉在线一区三|
99在线免费视频观看 |
国产2020乱码一二区|
97久久久人妻一区精品|
JIZZJIZZ日本高潮喷水 |
高跟丝袜日韩av|
91精品欧美综合在线观看最新|
97久久天天综合色天天综合色|
av毛片对白在线|
AV手机在线播放网站 |
91无码人妻一区二区成人AⅤ|
艹b视频在线观看一区三区|
东京热无码人妻系列综合|
最新久久亚洲精品中文字幕无码视频|
av在线播放国产区|
www.黄色视频网站|
91香蕉视频苹果版APP|
中文字幕一区二区三区日韩精品视频
|
91在线无码精品秘入口九色|
大香伊蕉在人线国产av|
97se国产综合精品一区二区|
国产成人激烈叫床声视频对白|
扒开腿挺进湿润的花苞hd视频
|
www日本在线视频|
成人无码一区二区三 |
97中文字幕无l码网址 |
东京小日无码在线|
苍井空无码在线一区二区 |
中文字幕无码高清视频|
aⅴ色窝窝男女爽爽a片 |
成人国产毛片2022年|
八重神子ちゃんが部下を腿法|
高清热播韩剧美剧全集 |
波多野吉衣电梯2|
99精品免费在线|
国产成人精品必看|
国产69精品久久久久不卡|
国产91精品麻豆|
成人短视频大全 |
91亚洲精品福利在线播放|
2021最新热播日韩无码|
av午夜福利网址|
国产办公室秘书无码精品99 |
99精品久久久久久久婷婷 |
91精品综合久久久久久蜜桃|
40分钟在线观看免费|
成年网站未满十八禁免费无码|
成人免费视频深夜视频在线看网站
|
不卡在线国产精品|
自拍区欧美激情校园另类|
成人免费视频深夜视频在线看网站|
福利姬国产精品一区在线|
中文字幕在线播放视频|
97公开在线视频|
国产av中国国产精品|
www.成人永久免费视频|
国产成人AV一区二区三区在线观看|
办公室人妻滋味2|
a级毛片在线播放|
八戒八戒在线视频|
91久久福利国产成人精品|
成人av毛片免费在线观看|
国产 欧美 中文字幕 日韩|
高清久久久中文字幕|
91亚洲精品免费|
91精品乱码久久|
高清电影在线播放|
69精品人妻久久久久久|
成人乱码一卡二卡3卡|
管鲍之交分拣中心未满十八岁
|
自拍偷拍专区一区二区
|
超清免费在线观看|
99精品国产一区二区电影|
大屁股大乳丰满人妻呻吟|
91精品免费在线播放视频|
丁香啪啪综合成人亚洲小说|
大地影视MV高清视频|
吃你私下的男人是爱你不|
自拍偷拍亚洲欧美中文字幕|
40分钟在线观看免费|
国产91在线视频在线观看|
av网址麻豆精品免费|
91大神娇喘女神疯狂在线|
JAPANESE日本爆乳巨大|
中文字幕视频xx片|
a欧美特黄日韩大片免费观看|
东京热毛片不卡二三区|
超清纯白嫩大学生无码网站 |
成人午夜性a级毛片免费|
波多野吉衣在线电影|
高H无码大尺度肉免费视频|
国产爆乳在线观看|
国产A级一级毛片|
av免费在线观看免费|
超碰白浆国产在线观看|
av午夜福利网址|
成熟丰满熟妇高潮XXXXX|
爆乳熟妇一区二区三区霸乳百度|
丰满少妇人妻无码13p在线|
av日韩精品一区在线观看|
国产AV国片精品JK制服|
91手机看片国产永久免费|
18禁动漫美女禁处被爆桶出水|
www.日韩欧美国产|
A片人人澡C片人人妻蜜臀|
打扑克又叫视频软件|
中文字幕亚洲成人一区|
成人毛片在线观看|
91人妻人人澡人人爽人人|
成人免费视频视频在线不卡|
97影院在线理论 |
大地资源影视中文版|
白天偷拍亚洲自怕|
公粗一晚六次挺进我密道视频|
成人福利av网站|
草莓视频午夜影院 |
91精品丝袜久久久久久|
99久热这里只有精品|
成人毛片18女人毛片免费 |
国产不卡一区二区免费|
办公室强伦片免费看|
91欧美精品午夜性色福利在线|
按摩A级毛片免费|
91久久精品无码一毛片|
69久久国产亚洲精品嫩草|
成人福利电影在线观看|
91精品综合久久久久久蜜桃|
成人国内精品久久久久一区|
www 国产 日韩 亚洲|
波多野结衣在线观看3人|
国产009精彩视频录像|
av一区三区二区|
91视频入口网址|
不卡无码人妻一区二区三区下载|
91尤物國產尤物福利|
91精品欧美一区二区三区综|
中文字幕一级AV |
国产91高清免费|
成年轻人网站色直接看|
俺去也理论资源站|
18禁黄色成人网站|
99久久国产精品免费免费|
2021年国产成年视频 |
成年一级毛片免费网站|
69人妻精品中文字幕|
成年女人www国产精品|
2016手机看欧美日韩一本到|
www.欧美日本在线观看 |
打扑克不盖被子床上运动软件下载
|
丰满女人的毛片久久久久久|
91在线精品中文字幕在线|
av天堂资源一区二区|
大学生一级毛片高清版|
丁香花视频免费播放|
av播放片在线观看|
成年人视频在线观看|
99爱视频精品免视看|
床震吃胸膜奶免费视频|
WWW桔色成人COM|
成人免费无码大片a毛片软件
|
AV综合网站一区 |
痴母手机在线中文字幕。|
髙清无码一级爱a视频|
99久久精品熟女高潮|
97影院在线观看|
51vv视频免费观看视频 |
国产不卡最新视频|
丰满女人的毛片久久久久久|
爆乳上司JULIA中文字幕|
丰满少妇被猛烈高清播放|
成年视频xxxxx在线观看|
中文字幕永久区无码2021|
岛国美女全棵写真视频在线观看|
www.国产日韩欧美.com|
东京一本到熟无码磁力|
福利在线观看一区 |
高清无码免费一区|
成 人 网站免费变态|
最近更新中文字幕在线 |
成人av免费观看免费|
av在线亚洲网站|
分分操免费视频在线观看|
潮喷大喷水系列无码|
2017年亚洲天天爽天天噜|
中文字幕伊人精品|
中文字幕人妻丝袜美腿乱 |
av手机免费观看|
www.亚洲欧美日韩 |
高清日本一区二区三区久久|
成人免费在线观看h视频|
A年片在线观看免费观看大全下|
av无码乱码在线观看无码 |
成年女人www国产精品|
成人午夜在线黄色视频|
337p亚洲日本中国大胆69|
厨房里掀起岳的裙子|
91视频在线观看下载|
18禁美女裸体无遮挡免费网站
|
俺去也理论资源站|
佐佐木明希中文在线|
中文字幕亚洲欧美精品一区二区 |
中文字幕综合av一区二区三区|
中文字幕无码高清视频|
成年人看的免费视频 |
成人綜合亞洲歐美一區h|
99视频精品免费观看|
wwwav大帝在线视频|
国产成人精品a 视频|
国产AⅤ精品福利一区二区三区|
91色乱码一区二区三区|
99久久精品视频女互慰女内射|
高清国产成人在线播放网站|
成人做受视频试看60秒 |
91一区二区三区四区五区|
苍井空波多野结衣AA片 |
国产ⅤA免费精品高清在线观看
|
51vv视频免费观看视频 |
国产v亚洲v天堂无码 |
丁香色婷婷五月激情|
99精品99国产不卡|
中文字幕在线亚洲精品|
av天堂国产免费|
高清国产天干天干天干不卡顿
|
大肉大捧一进一出好爽视频动漫
|
吃你私下的男人是爱你不|
成人在线观看福利视频|
波多野结衣中文字幕一区二区三区 |
国产爆乳福利视频|
成人国产av精品久久久久|
YY880高清影院|
国产av一区二区三区香焦
|
成人97在线观看免费高清|
jizz在线观看免费|
国产 欧美 中文字幕 日韩|
成人高清在线播放|
国产边打电话边做对白在线|
最近中文字幕乱码第一页|
a欧美特黄日韩大片免费观看|
成人精品动漫www免费看|
成人在线观看黄色av|
99精品视频只有精品|
99在线免费视频观看 |
3d动漫精品啪啪一区二区 |
99在线免费视频观看 |
99视频在线免费|
俄罗斯13女女破苞视频|
91香蕉亚洲国产一二三区 |
丁香花视频免费播放|
最新日韩av成人一区二区|
av天堂资源一区二区|
99国产一区二区香蕉|
成年女人喷潮毛片免费播放一|
中文字幕一区2区3区乱码在线|
97人人超视频在线观看|
福利视频一区二区牛牛|
俄罗斯一级污AAA片|
97超视频在线观看日韩|
www.日韩欧美国产|
福利国产小视频微信在线直播|
2025年国产精品看视频|
最新在线观看国产网站|
成年人网址日本一区二区|
av高清在线一区二区三区|
97国产精品人妻无码免费 |
91手机在线日韩|
成人免费看毛片视频 |
不戴套干已婚少妇|
99视频国产精品免费看|
丁香五月天综合网|
草莓app深夜释放自己|
аⅴ资源中文在线天堂|
成人高清免费在线 |
av日韩在线免费|
高清久久久中文字幕|
91影视安卓最新版下载|
成年人网址日本一区二区|
www.久久国产视频|
最新最热中文字幕|
99爱视频精品免视看|
67194成在线观看免费 |
91自拍偷拍在线|
2021年国产成年视频 |
春水堂视频app新春版下载|
2020最新精品极品自拍|
粉色视频视频APP免费观看|
啊轻点灬太粗嗯太深了快三|
大陆一级毛片免费|
高潮无码专区喷水|
丰满少妇被猛烈进入无码|
成人a∨欧美大片|
7788在线观看免费播放|
99久久精品国产免看国产|
自拍区欧美激情校园另类|
成人动漫一区网站免费在线观看|
成人爽a毛片免费啪啪2023|
国产a级片一级毛片|
丰满少妇人妻HD高清果冻传媒|
草莓视频污在线观看|
99精品国产高清一区二区三区|
91精品国自产在线播放|
91干综合亚洲 |
99久久精品免费视频|
成人AV片无码免费天天看 |
办公室人妻滋味2|
草莓免费在线观看|
成人精品国产亚洲|
爆播国产三级片在线视频|
白天偷拍亚洲自怕|
91中文字幕亚洲国产|
啊v日本在线播放|
最新亚洲中文在线播放|
91视频福利社区|
给我免费播放片国语电影|
99精品免费在线|
苍井空波多野结衣AA片 |
波多野42部无码喷潮BT种子|
中文字幕日韩精品精品一区|
2021国产麻豆剧传媒免费下载
|
成年女人www国产精品|
中文字幕一区二区久久|
成人在线视频亚洲国产|
AV有码中文字幕 |
91日韩电影免费在线观看|
成人免费欧美国产日韩|
成人做受视频试看60秒 |
91国语精品福利自产拍 |
综合无码中文字幕第2页亚洲
|
高清国产天干天干天干不卡顿
|
国产91极品福利手机观看|
WW国产人妻人伦精品|
惨遭蹂躏的大学校花|
91久久精品国产区二区|
ass白俄罗斯大肥妇pics|
国产18成人免费视频|
99午夜啪啪日本熟妇乱子?片|
2020无码专区人妻系列日韩|
99热这里只有精品8|
91干综合亚洲 |
国产a级黄片的视频|
98夜夜澡人人爽人人喊欧美|
综合精品无码在线观看|
中文字幕无码一二三|
草草久久97超级碰碰碰免费|
91欧美精品午夜性色福利在线|
99久久精品免费观看国产欧美日韩|
A级黄色片免费观看|
综合精品一区二区在线观看
|
俄罗斯13女女破苞视频|
91在线免费观看国产电影|
中文字幕日韩精品在线播放|
国产99久久久国产精品~~牛|
91久久精品人人人妻人69|
md豆传媒一二三区进站口在线|
成人免费黄色网站无毒|
成人依依网站亚洲综合久 |
5a级动作片在线观看 |
综合无码三级乱伦|
91亚洲精品免费|
丰满农村熟女大码|
91精品亚洲影视在线观看|
91久久香蕉国产熟女视频|
91亚洲国产日韩欧美在线播放|
成人 福利在线观看|
管鲍之交分拣中心未满十八岁|
yt740樱桃最新视频 |
丁香久久五月婷婷社区|
99视频精品免费观看|
丰满少妇被猛烈进入无码|
av中文字幕潮喷在线观看|
丰满女人的毛片久久久久久
|
国产av无遮挡喷水白浆桃花 |
都市人妻激情亚洲一区二区三区
工口全彩肉肉无遮挡全彩无码
|
成年网站未满十八禁免费无码
|
97三级小视频在线观看|
800av在线播放|
被滋润的少妇疯狂呻吟|
99这这里只有精品|
大香伊人久久精一飞二飞|
风韵犹存沙发69国产|
中文字幕无码专区人妻出轨系列|
18禁美女裸体无遮挡免费网站 |
91视频在线观看下载|
爱爱欧美视频一区二区三区|
中文字幕手机在线播放|
91大神娇喘女神疯狂在线|
国产成人AV福利在线播传媒|
91午夜福利网爆门|
成年午夜免费影院|
初高中生洗澡自慰高清网站|
大学生粉嫩无套流白浆 |
91视频软件APP|
AV无码无在线观看免费 |
国产SUV精品一区二|
18禁白丝JK自慰喷水无码|
18未满禁止免费69影院|
成人夜晚爱做免费观看|
变态另类天堂无码|
99这这里只有精品|
18男同志gay亚洲|
69堂免费视频精品|
福利姬国产精品一区在线|
中文字幕一区婷婷久久|
www亚洲AV无码乱码精品国产福利
成人免费视频一区二区
|
99精品视频免费在线观看|
丁香婷婷综合久久狠狠爱|
99精品国产手机免费观看|
国产av无遮挡喷水白浆桃花 |
www.日本免费一区二区|
www.日本免费一区二区三区|
18以下禁止观看的1000部视频|
91在线无码精品秘入口九色|
WW国产人妻人伦精品|
成人91福利在线观看|
成人福利午夜A片|
艹b视频在线观看一区三区|
18禁美女裸体无遮挡免费网站 |
99亚洲综合精品 |
本道高清无码不卡在线视频播放DV|
成人免费a级毛片高清视频|
7788成年網站免費觀看|
岛国av中文字幕影音先锋|
国产不卡一区二区|
91人妻一区二区久久久精品免费|
91美女秘片黄在线观看|
草莓视频成年app|
被按摩的人妻中文字幕97|
福利社免费一区二区三区|
波多野结衣 亚洲无码|
91传媒蜜桃香蕉在线观看|
www色哥哥com|
成人97在线观看免费高清|
成人性做爰aaa片免费视频|
国产A级一级毛片|
91猎奇在线观看|
2020最新久久久视精品爱|
成人国内精品久久久久一区|
国产91美女视频一区二区|
91国语精品福利自产拍 |
都市激情亚洲91|
丁香花视频完整版在线观看 |
99久久精品免费观看国产欧美日韩
|
国产成人精品高清片|
91久久人澡人人添 |
91精品欧美一区二区三区综|
最近中文视频高清|
惨遭蹂躏的大学校花|
av天堂网avtt|
A片粗大的内捧猛烈进出动态图片|
大香蕉1国产av一区二区|
中文字幕一区二区三区av解说|
不卡国产在线观看|
成人高清在线播放|
最美情侣中文字幕视频|
91一区二区三区四区五区|
中文字幕综合av一区二区三区|
MM1313亚洲精品无码久久 |
成全在线观看免费完整|
成人做爰A片免费看黄冈|
国产成人91成人精品看片|
91精品国产八戒影视|
波多野吉衣在线电影|
99亚洲综合精品成人网色播 |
周末同床中文字幕在线看|
91精品视频网站|
av一本一道中文字幕|
高清少妇一区二区三区视频|
爆乳放荡的女医生BD在线观看|
511麻豆视传媒精品av|
99久久精品视频女互慰女内射|
400部国产精品偷自产在线|
超碰伊人久久精品青草热|
粉色视频视频APP免费观看|
打扑克又叫视频软件|
成人在线免费播放|
成 人 免 费 黄 色 网 站 无 毒
8x8永久华人免费观看
|
104国产一级拍拍视频|
99精品视频在线观看.|
98夜夜澡人人爽人人喊欧美|
中文字幕在线观看国产精品|
91视频亚洲一区|
911吃瓜群众爆料|
被老外添嫩苞添高潮NP|
99精品国产福利在线观看|
高H无码大尺度肉免费视频|
超清纯白嫩大学生无码网站 |
成人綜合亞洲歐美一區h|
中文字幕一二区熟女avtv|
国产超碰青青在线|
3d肉脯团qvod|
成年免费A级毛片免费看无码|
97在线免费看视频|
99精品国产一区二区电影|
av天堂精品久久久久暴力|
97影院在线观看|
97人妻免费起碰公开|
中文字幕亚洲日韩精品一区无码|
成人一二三区视频|
成人看片免费观看|
波多野洁衣家庭教师|
国产a级中文字幕|
成熟丰满熟妇av无码区|
成年女人午夜特黄特色毛片免|
滋润BBWWBWWBBWW |
成年美女黄网站18禁免费APP|
91香蕉视频苹果版APP|
国产91精品一区二区蜜臀|
99精品国产手机免费观看|
96精品伊人久久久大香线蕉|
国产成+人+综合+亚洲|
国产AV旡码专区亚洲AV |
自在线观看h片国产播放免费|
东京小日无码在线|
91av国产高清在线|
国产 精品www|
7777久久亚洲中文字幕蜜桃|
18禁无遮挡免费视频网站视频|
中文字幕一区婷婷在线|
bt樱桃磁力搜索|
成 人 色综合 综合网站|
草莓视频app成人版|
gv无码免费无禁网站男男|
99J久久精品久久久久久|
91青青草视频免费观看|
疯狂做受XXXX高潮欧美老妇|
综合无码三级乱伦|
自拍区欧美激情校园另类|
电影天堂在线观看高清|
国产av亚洲精品ai换脸电影|
高清无码观看→日韩精品亚洲首页
|
丁香婷婷激情五月天欧美图|
成年a级毛片免费观看秋霞|
字幕在线免费网站|
91日韩电影免费在线观看|
18国产在线播放观看 |
中文字幕网站免费在线观看|
3d肉蒲团完整版下载|
成人午夜国产十八禁激情在线观看|
成人性生交大片免费看久久 |
97人人超碰国产精品最新|
99亚洲综合精品成人网色播 |
波多野结衣在线观看3人|
成人91福利在线观看|
八个少妇沟厕小便漂亮各种大屁股|
91自拍偷拍在线|
最近中文字幕av在线高清|
3D动漫AV特黄在线观看网站
|
最近最好最新2018中文字幕免费
|
草莓app深夜释放自己|
中文字幕日产无码一区久久久久久
|
97超碰资源总站|
国产成人精品必看|
99热这里只有精品8|
中文字幕日产无码一区久久久久久|
97日日碰曰曰摸日日澡|
av大片国产免费看|
91精品国自产在线|
99久久国产露脸国语对白 |
91麻豆精品国产先锋影音 |
A年片在线观看免费观看大全下|
妇女性内射冈站HDWWW000|
97久久精品久久伊人精品|
97三级小视频在线观看|
成人av免费观看免费|
超清免费在线观看|
91干综合亚洲 |
最新最近中文亚洲av字幕 |
中文字幕在线观看免费观看
|
99久久久国产精品免费爽爽|
成人a毛片免费观看网站|
达达兔影院推理片|
中文字幕网站免费在线观看|
丰满少妇无套内谢A片小说软件|
成人区亚洲区无码区在线|
7086亚洲精品无码合集|
?v免费在线看的网站|
国产18成人三级在线观看|
99热青青草超碰在线|
爱国产精品久久久久久久|
最好看的2018中文2019|
91视频入口网址|
?v免费在线看的网站|
国产av不卡中文字幕|
50款不良网站下载进入窗口|
国产91中文字幕|
国产成人91成人精品看片|
疯狂做受XXXX高潮欧美老妇|
福利视频一区二区牛牛|
最新一区二区三区在线观看|
丰满少妇被猛烈进入无码|
91久久人澡人人添 |
俄罗斯13女女破苞视频|
91亚洲精品福利在线播放|
中文字幕在线不卡视频在线观看|
草莓视频成人免费网站|
91无码精品无码专区在线|
最近更新中文字幕手机版 |
91传媒理伦片在线观看|
最新在线不卡中文字幕|
成人动漫一区网站免费在线观看|
最近最新的日本免费 |
都市人妻激情亚洲一区二区三区 |
JZZIJZZIJ日本成熟少妇|
91色乱码一区二区三区|
97操射操射人人色|
91精品国产自产在线观看不|
成人 欧美 日韩 在线 |
91久久人澡人人添 |
91视频这里只有|
91香蕉视频在线观看高清|
惨遭蹂躏的大学校花|
91干综合亚洲 |
中文字幕日产无码一区久久久久久
|
97三级小视频在线观看|
成人黄色电影下载 |
被老外添嫩苞添高潮NP|
中文字幕无码一线二线三线|
国产 国语对白 露脸|
www日韩高清毛片免费观看|
ysl蜜桃色888网站|
国产AV综合A∨一区二区三区|
97久久精品人妻人人|
99国产精品毛片 |
aa大片成人免费网站|
国产a级黄片的视频|
91九色最新视频在线观看|
最近更新中文字幕一区二区|
啊舒服快啊啊亚洲无码视频互動交流 |
99久久久无码精品免费|
3d肉脯团qvod|
中文字幕手机在线播放|
丁香花在线影院观看在线播放|
av中文字幕在线观看性|
波多野结衣av手机在线观看|
成年女人午夜特黄特色毛片免|
91社区福利免费体验30秒|
18岁禁看的免费操片 |
CHINESE老女人老熟妇HD |
草莓视频18下载|
调教超级yin荡玩物学生h|
99精品久久久久中文字幕|
中文字幕一区婷婷在线|
成人精品高清不卡 |
办公室的秘密2中文字幕|
最新国产日韩涩视频下载|
苍井空三点高清线视频|
成人a毛片免费观看网站|
福利姬白浆AV导航|
佐佐木明希中文在线|
作爱视频免费在线观看|
www.日韩欧美国产|
中文字幕亚洲一区|
91精品欧美一区二区三区综|
91天堂在线视频 |
99热这里只有精品8|
ass白俄罗斯大肥妇pics|
av男人在线天堂网|
福利在线播放国产精在线|
a天堂无码秋霞网|
中文字幕熟女黄片|
成人福利免费视频|
草莓视频app入口|
中文字幕手机在线播放|
成人av天堂片在线观看|
最美情侣中文字幕视频|
自拍偷拍专区一区二区|
国产XXX视频在线观看软件|
最近更新中文字幕在线 |
md传媒哪里可以免费观看|
艹b视频在线观看一区三区|
成人av网址免费在线观看|
97中文字幕无l码网址 |
WWW桔色成人COM|
av毛片精品久久久|
91欧美精品午夜性色福利在线|
变态另类天堂无码|
成人在线免费播放|
成人精品一区日本无码网|
啊啊啊视频免费字幕午夜|
337p欧美日本超大胆艺术裸|
爱国产精品久久久久久久|
www高清无码日韩三级|
av网址麻豆精品免费|
91尤物國產尤物福利|
91尤物國產尤物福利|
成人免费看黄app涩涩|
国产av大片久久久|
www.黄色视频网站|
аⅴ资源新版在线天堂精品一级A毛片|
福利一区福利二区在线视频|
7777久久亚洲中文字幕蜜桃|
国产ts精品人妖系列|
国产999免费视频 |
av影片在线观看免费韩国|
成人乱码一区二区三区四区|
91无码人妻一区二区成人AⅤ|
heyzo高清中文字幕在线|
成人欧美一区二区三区黑人|
床震吃胸膜奶免费视频|
啊好深啊好大午夜视频麻豆|
草莓视频黄瓜视频|
粉嫩无码精品久久久久|
a欧美特黄日韩大片免费观看|
丁香啪啪综合成人亚洲小说|
国产a级片一级毛片|
不戴套干已婚少妇|
onlyyou成品短视频旧版|
99久久精品免费视频|
成人电线在线播放无码|
91人人澡人人妻人人精品|
最近中文字幕免费mv在线|
国产av熟女另类|
91成人免费观看|
国产91在线拍偷自揄拍|
岛国av中文字幕影音先锋|
www.国产午夜福利|
超级碰碰成人免费视频app
|
国产百合高潮视频在线观看
|
国产99视频在线观看|
91久久香蕉国产熟女视频|
最近中文视频高清|
暴力调教一区二区三区|
91无码人妻一区二区成人AⅤ|
18禁止观看免费私人影院|
7788在线观看免费播放|
JD又大又粗又硬受不了|
69资源在线观看|
成年片免费观看视频播放器|
草莓视频app下载无限看|
99国产精品毛片 |
国产v亚洲v天堂a亚洲|
最新亚洲中文在线播放|
八戒八戒在线视频|
成人大片免费在线视频观看
|
高清国产成人在线播放网站|
攻被保镖狂c呻吟爆汁bl|
大香蕉99在线观看|
国产成人二区在线观看|
99精品视频九九精品 |
fc2ppv视频在线观看 |
av日韩免费在线|
国产91视频在线观看|
高清无码免费一区|
成人论坛视频在线|
国产AV无码专区亚洲AV麻豆|
97在线免费看视频|
超碰av在线互动交流|
3d精品无码里番在线观看|
国产99视频在线观看|
337p亚洲日本中国大胆69|
高清少妇一区二区三区视频|
99午夜啪啪日本熟妇乱子?片|
成人亚洲国产高清精品一区不卡|
www.国产午夜福利|
91视频官方入口|
宝可梦沙奈朵的乳液网站|
波多野洁衣高清写真 |
91最新亚洲精品中文字幕 |
97三级小视频在线观看|
91在线午夜福利视|
91成人免费观看|
www.天堂在线资源|
av免费在线观看免费|
18岁禁看的免费操片 |
freex性日韩阿v精品一区二区三区
|
337P日本欧洲亚洲大胆69影院|
成人国产毛片2022年|
综合精品一区二区在线观看|
国产69精品久久久久不卡|
中文字幕在线播放视频|
公交车后车座的疯狂CGH|
中文字幕手机乱码一区二区|
99久久亚洲综合网精品全集观看|
最新精品国产偷自在线|
91素人搭讪系列|
av中文字幕在线观看性|
不卡在线国产精品|
51精品资源视频在线播放|
CHINESE老女人老熟妇HD |
成人毛片在线观看|
91亚洲欧美日韩国产|
被拉到野外强要好爽 |
国产av综合精品色区|
91传媒制作网站官网|
丰满少妇被猛烈进入无码|
啊啊啊国产欧美日韩在线观看|
大色网激情你懂的|
91美女精品网站 |
91视频福利社区|
2020最新精品极品自拍|
中文字幕在线播放视频|
疯狂做受XXXX高潮欧美老妇|
136fldh微拍视频旧版本|
草莓视频下载网站|
最近中文字幕高清字幕免费MV|
国产 又粗 又黄 又爽|
成人午夜福利大片|
av无码乱码在线观看无码
|
(无码视频)在线观看|
91精品福利在线 |
AV中文字幕高清中文|
gogogo高清免费观看中国|
91麻豆蜜臀国产自产在线观看
|
丰满的熟妇岳中文字幕|
成人亚洲色欲色www |
国产成人激烈叫床声视频对白|
HDSEXVIDEOS中国少妇|
做暧暧小视频黄色三级毛片|
WWW国产亚洲精品久久久|
成人在线视频亚洲国产|
国产成人AV无码精品嫩草免费|
国产成a人片在线观看视|
91色漫在线ios手机版安装
|
aV东京热强奸精品|
18禁网站精品久久久久|
国产成人8x网站视频|
国产爆乳福利视频|
丁香婷婷激情五月天欧美图|
最近中文免费字幕8|
成人18秘 免费av在线|
综合国产免费自拍|
国产百合高潮视频在线观看|
69人妻精品久久无人专区|
18禁黄网站免费 |
av中文字幕潮喷在线观看|
av天堂国产免费|
电影天堂在线播放|
傲风文学网无弹窗 |
超清有字幕完整版|
综合精品无码在线观看|
99精品视频免费热播在线观看|
中文字幕永久区无码2021|
AV免費網址在線觀看|
不卡视频在线国产|
成人福利午夜A片|
成人无码区免费A∨|
91人人澡人人妻人人精品|
91亚洲精品专区|
白嫩少妇HDXXXX性 |
3d肉蒲团完整版下载|
国产ⅤA免费精品高清在线观看 |
337p人体粉嫩胞高清大图视频 |
MM1313亚洲精品无码久久 |
大香蕉1国产av一区二区|
成人免费在线观看h视频|
成人三级视频在线观看|
中文字幕系列AV网最新|
成人论坛视频在线|
91探花国产在线观看|
初尝黑人巨砲波多野结衣在线观看
|
成年一级毛片免费网站|
www.久久久综合伊人|
av手机免费观看|
国产不卡一区二区免费|
2020年国产精品自拍视频 |
国产av日韩久久|
爆乳上司JULIA中文字幕|
成人无码区免费A∨|
成年视频xxxxx在线观看|
丰满人妻被插入中文字幕|
JLZZJLZZJLZ亚洲日本|
91在线免费观看国产电影|
18禁美女裸体无遮挡免费网站 |
成人亚洲色欲色www |
A片人人澡C片人人妻蜜臀|
av手机免费观看|
国产video亚洲成人毛片|
不卡精品在线观看 |
91午夜福利网爆门|
成人日韩欧美一级片|
717在线电影理论片被强|
18禁止爆乳挤奶头gif动态图|
91午夜福利国产 |
av在线国产盗摄ed|
gogogo高清免费观看中国|
中文字幕网站免费在线观看|
91社区国产在线|
国产79影院在线观看|
91中文字幕亚洲人妻|
国产爆乳无码一区二区麻豆|
91午夜福利国产 |
都市激情亚洲91|
中文字幕亚洲日本 |
2021年国产成年视频 |
国产阿v网站高清在线|
国产不卡一区二区|
成人Aⅴ免费视频在线观看网站|
成品人和精品人的区别在哪里|
7788成年網站免費觀看|
高清自拍少妇免费 |
91传媒制片厂官方入口|
中文字幕一区二区久久|
国产h片量多网站|
国产99久久精品在|
MD传媒免费观看在线|
2017年亚洲天天爽天天噜|
99久久综合狠狠综合久久|
www.欧美日本在线观看 |
巴西国模私拍大胆高清大图|
八戒影院午夜福利|
a在线 播放 导航|
光棍影院午夜伦理|
91蜜臀国产自产在线观看|
成年黄页网站大全免费无码|
成为国内精品小视频|
福利姬国产精品一区在线|
成人免费在线视频一区二区|
公交车后车座的疯狂CGH|
91av电影一区二区|
国产吧激情不卡在线观看|
91亚洲精品免费|
国产suv精品视频一区88|
中文字幕一区二区三区不卡在线|
www亚洲AV无码乱码精品国产福利|
边摸边吻挵进去免费视频|
成人福利午夜A片|
变态捡到女婴h养成调教|
福利姬液液酱高潮喷水白浆|
91久久夜色精品国产网站|
99爱视频精品免视看|
国产xxxxx在线观看视频|
91av电影一区二区|
福利视频一区二区牛牛|
511麻豆视传媒精品av|
成年美女黄网站色大片不卡|
MM131午夜福利在线观看 |
成人中文字幕免费|
国产成人91成人精品看片|
99热99re8|
777久久亚洲中文蜜桃|
jlzz大全高潮多水老师 |
成人网18免费视频|
成年人在线免费精品视频|
波多野结衣无码人妻三区|
99久久精品国产一区二区蜜芽|
97在线午夜免费视影院|
啊灬啊灬啊灬快灬深用口述|
中文字幕在线观看免费观看|
丁香啪啪综合成人亚洲小说|
99久久中出中文字幕|
成人免费欧美国产日韩|
俺去也理论资源站|
不卡无码人妻一区二区三区下载|
国产3级在线观看|
草莓视频app入口|
成人a毛片免费观看网站|
爆乳熟妇一区二区三区霸乳百度|
92成人午夜福利|
91精品欧美综合在线观看最新|
69堂免费视频精品|
国产vs日韩三级高清无码|
成人精品无码四虎影视av|
丁香久久婷婷综合精品|
岛国成人一区二区在线观看网址|
99精品国产高清一区二区三区|
91九色中文视频在线观看|
777久久亚洲中文蜜桃|
成人免费在线午夜|
光棍影院电影免费|
国产成人二区在线观看|
国产不卡在线观看区色婷婷|
疯狂欧美大伦交乱|
成人黄色视频下载|
中文字字幕在线中文人妖|
a级国产高清美女理论片|
超碰在线公开2021|
97精品人妻一区二区三区视频
|
成人精品动漫www免费看|
(无码视频)在线观看|
宝可梦沙奈朵的乳液网站|
国产成人AV无码精品嫩草免费|
99视频国产精品免费看|
成人綜合亞洲歐美一區h|
中文字幕伊人精品|
国产69精品亚洲黄片大全|
AV有码中文字幕 |
成人高清在线亚洲观看|
成人精品成人午夜福利|
成人av在线播放你懂的|
99久久精品久久久久久婷婷|
成年色黄APP下载|
中文字幕无码专区人妻出轨系列|
91久久精品人妻中文字幕|
大陆国产特级毛在线看|
丁香花在线影院观看在线播放|
av黄片毛片免费在线观看|
苍井空三点高清线视频|
粉嫩av一区二区三区免费观看 |
99亚洲综合精品成人网色播 |
高清日本一区二区三区久久|
99精品久久久久久久婷婷 |
最近日韩一级高清视频在线
|
99热99re8|
91视频入口网址|
www.日本免费一区二区|
丰满少妇一级毛片免费|
最近中文字幕免费完整视频高清1|
国产不卡一区二区|
videosg最新欧美另类|
成人午夜大香蕉视频在线观看|
粉嫩无码精品久久久久|
中文字幕无码无遮挡在线看|
傲风文学网无弹窗 |
中文字幕亚洲综合久久菠|
高清偷看美女撒尿mp4|
6677免费观看在线视频|
成年美女黄网站色大片不卡|
中文综合高清乱伦|
99精产国品一二三产区区别电影|
av免费在线观看免费|
超碰成人在线91|
综合无码中文字幕第2页亚洲|
电影天堂在线观看高清|
中文字幕日韩精品在线播放|
5g影院5g天天爽永久免费影院|
傲风文学网无弹窗 |
成人精品无码四虎影视av|
最近日韩一级高清视频在线|
东京热人妻系列无码专区|
gogogo高清免费观看中国|
高跟丝袜日韩av|
中文字幕系列AV网最新|
HDSEXVIDEOS中国少妇|
丁香久久五月婷婷社区|
033亚洲国产乱人视频|
337p粉嫩胞人体高清视频免费|
啊啊啊视频免费字幕午夜|
福利偷拍一区二区|
97在线播放视频|
中文字幕手机在线播放|
91精品国自产在线|
2018日韩视频中文字幕|
成人国产精品秘果冻传媒在线|
成人免费在线午夜|
成人午夜A片999影视 |
草莓视频在线观看色|
岛国av在线免费观看一区二区|
jizz动漫精品视频免费观看 |
都市人妻激情亚洲一区二区三区 |
大肉大捧一进一出好爽视频动漫|
91蜜臀国产自产在线观看|
av黄色在线免费|
成年人视频大全免费观看|
99国产精品久久久久久久成人|
超碰av在线互动交流|
粗大黑人巨精大战欧美成人免费看 |
不卡国产在线观看|
岛国av毛片免费在线观看|
都市人妻激情亚洲一区二区三区 |
中文字幕在线不卡视频在线观看|
国产99久久久国产精品~~牛|
成人福利午夜A片|
91久久夜色精品国产网站|
91亚洲国产日韩欧美在线播放|
中文字幕在线视频制服丝袜|
91热视频在线观看这里是精品|
成人綜合亞洲歐美一區h|
中文字幕日韩亚洲|
成人 欧美 日韩 在线 |
91久久精品99久久|
大学生粉嫩无套流白浆 |
www.亚洲欧美日韩 |
第一页综合婷婷中文字幕|
国产18成人三级在线观看|
成人av在线播放你懂的|
K丅v小伙和服务生囗交|
综合亚洲欧美精品日韩|
公么吃奶摸下面好舒服|
3D动漫AV特黄在线观看网站|
最新国产剧情在线不卡|
成年色黄APP下载|
波多野结衣中文字幕免费视频|
wwwcom毛片|
91社区国产在线|
中文字字幕在线中文人妖|
国产办公室秘书无码精品99 |
99视频精品全部免费 |
成年片免费观看视频播放器|
公交车后车座的疯狂CGH|
中文字幕一级AV |
2019免费一级黄片|
超碰在线公开2021|
大香伊人久久精一飞二飞|
潮喷大喷水系列无码|
被男狂揉吃奶高潮60分钟|
A级黄色片免费观看|
高清热播韩剧美剧全集 |
MD传媒免费观看在线|
A∨在线免费不卡可看|
7878成人国产在线观看|
中字幕视频在线永久在线观看免费|
成人亚洲电影在线天堂|
成人午夜福利片免费观看|
波多野结衣AV高清中文字幕 |
丰满少妇一级毛片免费|
中文字幕视频xx片|
岛国人妻视频在线|
啊好深啊好大午夜视频麻豆|
多人性战交疯狂派对|
朱竹清~你兔子好软水好游戏
|
暗呦交小U女国产精品视频 |
北条麻妃一区二区三区av高清|
最新国产牛牛热在线视频|
91精品欧美一区二区三区综|
成年人视频在线观看|
福利姬液液酱喷水视频在线观看|
爆乳放荡的女医生BD在线观看|
国产91视频在线观看|
暗呦交小U女国产精品视频 |
aaa午夜一级毛片免费在线播放|
369看片天堂你懂的电影|
综合精品无码在线观看|
最近更新中文字幕一区二区|
高清国产天干天干天干不卡顿|
91午夜福利国产 |
91麻豆蜜臀国产自产在线观看|
2017年亚洲天天爽天天噜|
97色精品一区二区在线观看|
2024国产精品一区在线观看|
最近中文字幕亚洲 |
99久久久国产精品调教|
白嫩少妇HDXXXX性 |
91免费无码国产在线观 |
公粗一晚六次挺进我密道视频|
91自拍偷拍在线|
岛国成人一区二区在线观看网址|
成人免费视频视频在线不卡|
波多野42部无码喷潮BT种子|
最新最热中文字幕|
草草久久97超级碰碰碰免费|
福利一区二区在线|
91香蕉视频软件|
juliaann无码丰满熟妇 |
99爱视频精品免视看|
91视频这里只有|
18禁止观看免费私人影院|
www色哥哥com|
国产69精品毛片一区二区|
中文字幕亚洲精品伦理|
av网址麻豆精品免费|
onlyyou成品短视频旧版
|
97影视app下载|
91亚洲欧美日韩国产|
国产91色在线视频|
99亚洲综合精品成人网色播
|
MM1313亚洲精品无码久久 |
3d肉蒲团完整版下载|
69久久久久久91精品人妻|
91av电影一区二区|
动漫精品中文字幕无码三区|
拨开丁字裤揉捏H|
91嫩草久久久精品影院|
作爱视频免费在线观看|
а天堂8中文最新版在线官网|
91嫩草久久久精品影院|
最近亚洲中文字幕 |
www.日韩欧美国产|
91成人免费观看|
达达兔影院推理片|
yy6080午夜一级毛片超清|
综合精品一区二区在线观看
|
动一动舒服网站在线观看|
26uuu另类亚洲欧美日本|
福利500免费导航|
97国产激情视频在线|
中文字幕一区二区在线免费|
K丅v小伙和服务生囗交|
波多野洁衣高清写真 |
高清电影在线播放|
成人精品无码四虎影视av|
成人免费看黄app涩涩|
啊片网站在线观看|
AV无码波多野一级毛片|
91手机在线日韩|
成人午夜性a级毛片免费|
草莓视频app成人版|
成人爽免费视频在线观看|
超碰av在线互动交流|
国产av一区二区三区香焦|
18禁久久精品乱码|
中文字幕欧美亚洲一区|
中文字幕日韩亚洲|
中文字幕一区婷婷在线|
波多野结衣 亚洲无码|
国产边打电话边做对白在线|
91手机在线日韩|
大屁股大乳丰满人妻呻吟|
97久久久人妻一区精品|
91大神精品视频在线观看|
国产v亚洲v天堂无码 |
18禁止观看免费私人影院|
mm在线视频免费看|
大陆老太交xxxxxhd在线 |
啊啊啊国产欧美日韩在线观看
|
高清毛片在线播放|
69久久久久久91精品人妻|
91大神精品视频在线观看|
99午夜啪啪日本熟妇乱子?片|
av天堂国产免费|
成人亚洲色欲色www |
最近2019免费中文第一页 |
18禁黄色成人网站|
91av电影一区二区|
第一次深夜视频观看网址|
69久久久久久91精品人妻|
成人欧美在线视频免费观看|
国产av传媒中文字幕|
99精品国产福利在线观看|
综合久久99 精品亚洲婷婷|
龚玥菲三级在线看|
白嫩少妇HDXXXX性 |
国产av麻豆mag剧集 |
7777久久亚洲中文字幕蜜桃|
99久久无码一区人妻A片 |
成年a级毛片免费观看秋霞|
八个少妇沟厕小便漂亮各种大屁股|
av无码乱码在线观看无码
|
2021国产麻豆剧传媒免费下载|
字幕在线免费网站|
锕锕锕锕锕锕锕锕好痛app|
高H无码大尺度肉免费视频|
K丅v小伙和服务生囗交|
98热精品视频在线观看|
岛国成人一区二区在线观看网址|
成人A区在线观看污|
成人激情一区二区电影|
成人激情一区二区电影|
中文字幕人妻丝袜美腿乱 |
东京热人妻系列无码专区
|
中文字幕亚洲人妻一区二区 |
成年女人www国产精品|
A片在线免费观看 |
成人无码区免费A∨|
第一福利视频500|
av中文字幕在线不卡|
国产不卡v片在线观看|
丰满尤物贵妇颤抖潮喷|
超碰av在线互动交流|
福利姬液液酱喷水|
2025中文字字幕|
99精品国产高清一区二区三区|
高清欧美日韩在线|
WWW桔色成人COM|
成年视频xxxxx在线观看|
www.日韩欧美国产|
电影天堂在线观看高清|
91视频软件APP|
aaaa无码国产在线观看|
国产成人二区在线观看|
龚玥菲三级在线看|
最新国产剧情在线不卡|
40分钟在线观看免费|
99久久精品国产免看国产|
国产不卡在线视频 |
草莓视频黄瓜视频|
中文字幕网站免费在线观看|
穿裙子等不及在车里就要了6次|
99热青青草超碰在线|
国产a级片一级毛片|
成人在线激情视频 |
国产WW久久久久久久久久 |
91精品一区二区三区综合在线|
中文综合高清乱伦|
大学生粉嫩无套流白浆 |
中文字幕网站免费在线观看|
超碰国产公开caoprom|
等不及在车里就来开始了软件|
99久久精品国产麻豆的更新时间|
av日韩在线免费|
成人动漫一区网站免费在线观看|
91久久香蕉国产熟女视频|
成人c视频免费高清在线观看|
91精品国自产在线|
国产A级一级毛片|
成人免费又大又粗毛片|
kedou在线视频国产|
国产不卡最新视频|
av高清在线一区二区三区
|
jlzz大全高潮多水老师 |
99国产精品欧 |
成人成人一区二区三区|
中文字幕亚洲综合久久菠|
97色伦国产在线|
1024人妻一区二区三区69|
成人中文字幕免费|
中文字幕亚洲成人一区|
91久久精品人妻中文字幕|
2025年国产精品看视频|
AV手机在线播放网站 |
成人亚洲精品久久 |
床震吃胸膜奶免费视频|
中文字幕无码一线二线三线|
草莓av福利网站导航|
中文字幕熟女黄片|
91猎奇在线观看|
18禁无遮挡久久精品 |
最美情侣2019中文版|
东京热高清无码精品|
超清纯白嫩大学生无码网站 |
91深夜福利免费观看网站入口|
av免费在线观看无需播放器|
丰满少好被猛烈进入高清播放|
粗大黑人巨精大战欧美成人免费看
|
公交车后车座的疯狂CGH|
91在线精品中文字幕在线
|
2021最新热播日韩无码|
AV免費網址在線觀看|
中文字幕一区二区久久|
最新国产牛牛热在线视频|
91精品乱码久久|
国产不卡无码免费视频网 |
被男狂揉吃奶胸60分钟视频|
国产Chinese男男GAy视频网|
打扑克又叫视频软件|
JAPANESE日本爆乳巨大|
成人亚洲电影在线天堂|
A片高潮抽搐揉捏奶头视频|
国产91极品福利手机观看|
777米奇色888狠狠俺去啦|
91传媒理伦片在线观看|
波多野吉衣在线电影|
成人无码H动漫在线视频网站
|
91精品免费国产高清在线
|
国产91视频在线观看|
99999久久久久久亚洲 |
JIZZJIZZ日本高潮喷水 |
被男狂揉吃奶胸60分钟视频|
草莓视频下载app视频观看|
91成人在线视频精品|
综合激情中文字幕一区|
AV综合网站一区 |
周末同床中文字幕在线看|
粉色视频视频APP免费观看|
国产爱豆剧传媒在线观看|
91久久九九精品国产综合|
69国产成人网站|
调教妻弟的日日夜夜|
中文字幕亚洲日韩精品一区无码
|
18禁白丝JK自慰喷水无码|
成·人免费午夜视频含羞草
|
中文字幕视频xx片|
中文字幕一区二区三区乱码在线|
videosg最新欧美另类|
91精品一区二区三区综合在线|
中文字幕亚洲综合 |

 聯(lián)系我們
聯(lián)系我們